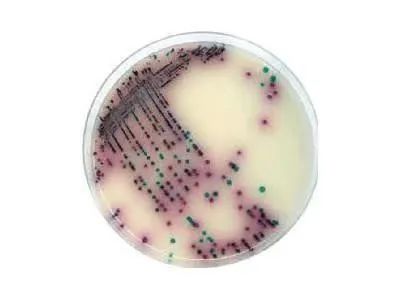
微信图片_20220725154741.jpg

今年的夏天,实在热!热!热!,相信大家都在靠吹空调“续命”。然而,空调长时间不清洗容易滋生细菌,公共场所大多门窗关闭,空气流通不畅,若长时间待在空调房内,易患“空调病”。


鼻塞、乏力,症状像感冒又不是感冒,就是“空调病”吗?医学上其实并没有一种病叫作“空调病”,这是一个社会学的病名,通常与空调的不恰当使用有关。轻症可出现类似感冒样症状,重症可出现高热、神志模糊、呼吸困难,肺部感染等症状。其中,嗜肺军团菌是“空调病”的主要病原菌之一。

嗜肺军团菌是一种需氧革兰阴性菌,可在20~42℃条件下生长,最适生长温度为35~37℃,每年7、8、9月军团菌感染较高发,广泛存在于自然界水体中,其主要传染源是水体和空调冷凝水,主要传播途径气溶胶吸入。这种菌有15个血清型,最常致病型为血清Ⅰ型。
嗜肺军团菌易感染人群
据2021年文献社区获得性军团菌肺炎39例临床分析,39例患者中87.2%合并有基础疾病[1]。

西安区域医学检验中心
嗜肺军团菌检测方法有哪些:
☝ 军团菌培养
1.嗜肺军团菌培养:金标准,培养要求苛刻,在含有磷酸铁和L-半胱氨酸的F-G琼脂培养基或缓冲的活性炭酵母提出物(BCYE)琼脂培养基上生长,需培养1周以上,如需培养请提前预约。标本类型:血、肺泡灌洗液、痰和胸腔积液。

☝ 军团菌抗原检测阳性
2.军团菌抗原检测:一线诊断方法,尿抗原在发病2-3天可以测得,2个月后转阴。标本类型:尿液/肺泡灌洗液。

3.呼吸道病毒抗体九联检检测:标本类型:血清

4.13种医院感染病原体检测:标本类型:痰液/肺泡灌洗液
5.病原宏基因组二代测序(mNGS):标本类型:血、肺泡灌洗液、痰和胸腔积液。
1、首选大环内酯类或氟喹诺酮类,四环素类、利福平等也有效,青霉素类、氨基糖甙类、头孢菌素类对本病无明显疗效。
2、维持水和电解质的平衡、呼吸衰竭时人工呼吸器的应用、休克时血管活性药物和其他抗休克措施、急性肾功能衰竭时的透析疗法均为重要的治疗措施。
定期清洗空调(包括易忽略的车载空调),必要时可使用消毒剂除菌,防止细菌滋生,在使用空调前,先开窗通风10分钟,空调温度设在26℃左右。
长期在空调室内工作和学习的人群,要适当进行户外活动,多喝开水,防止干燥,加速体内新陈代谢。
适当锻炼,增强体质,通过提高免疫力来预防夏日“空调病”。
如有检测嗜肺军团菌的需求,可在工作时间联系西安区域医学检验中心惠先生(17691337638)咨询。
参考文献
[1]庞丽,张杜超,秦崇,刘佳,潘磊. 社区获得性军团菌肺炎39例临床分析.2021.标记免疫与临床.28(5):748-752
文 | 微生物部 李妮妮、陈玉芊
审校 | 徐修礼
编辑 | 曹星星
部分图片来源 | 摄图网